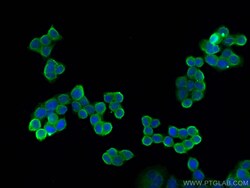
CD59 Mouse Monoclonal Antibody, Proteintech:Antibodies:Primary Antibodies

missing translation for 'onlineSavingsMsg'
Learn More
Learn More
CD59 Mouse Monoclonal Antibody, Proteintech
Mouse Monoclonal Antibody
129.00€ - 349.00€
Specifications
| Antigen | CD59 |
|---|---|
| Clone | 1E3A1 |
| Concentration | 1000 μg/mL |
| Applications | Western Blot, Immunohistochemistry, Immunocytochemistry/Immunofluorescence, Immunofluorescence, ELISA |
| Classification | Monoclonal |
| Code produit | Marque | Quantity | Prix | Quantité et disponibilité | |||||
|---|---|---|---|---|---|---|---|---|---|
| Code produit | Marque | Quantity | Prix | Quantité et disponibilité | |||||
|
30235531
|
Proteintech
68222-1-IG-150UL |
150 μL |
 410.00€ 349.00€ / 150µL Save 61.00€ 14% Off |
Please sign in to purchase this item. Need a web account? Register with us today! | |||||
|
30237518
|
Proteintech
68222-1-IG-20UL |
20 μL |
 145.00€ 129.00€ / 20µL Save 16.00€ 11% Off |
Please sign in to purchase this item. Need a web account? Register with us today! | |||||
Description
The CD59 antibody from Proteintech is a mouse monoclonal antibody generated with recombinant protein of human CD59. This antibody recognizes human antigen. The CD59 antibody has been validated for the following applications: WB, IHC, IF/ICC, IF-P, ELISA analysis.Spécification
| CD59 | |
| 1000 μg/mL | |
| Monoclonal | |
| Liquid | |
| RUO | |
| 966 | |
| Recombinant Protein | |
| Primary | |
| Store at -20°C. Stable for one year after shipment. |
| 1E3A1 | |
| Western Blot, Immunohistochemistry, Immunocytochemistry/Immunofluorescence, Immunofluorescence, ELISA | |
| Unconjugated | |
| Mouse | |
| Human | |
| 16.3A5; 1F5; EJ16; EJ30; EL32; FLJ38134; FLJ92039; G344; HRF-20; HRF20; MAC-IP; MACIF; MEM43; MGC2354; MIC11; MIN1; MIN2; MIN3; MIRL; MSK21; p18-20 | |
| IgG2b | |
| Protein A purification | |
| Monoclonal Antibody |
Vous avez repéré une opportunité d'amélioration ?Partager une correction de contenu
Correction du contenu d'un produit
Veuillez fournir vos retours sur le contenu du produit en remplissant le formulaire ci-dessous.
Nom du produit